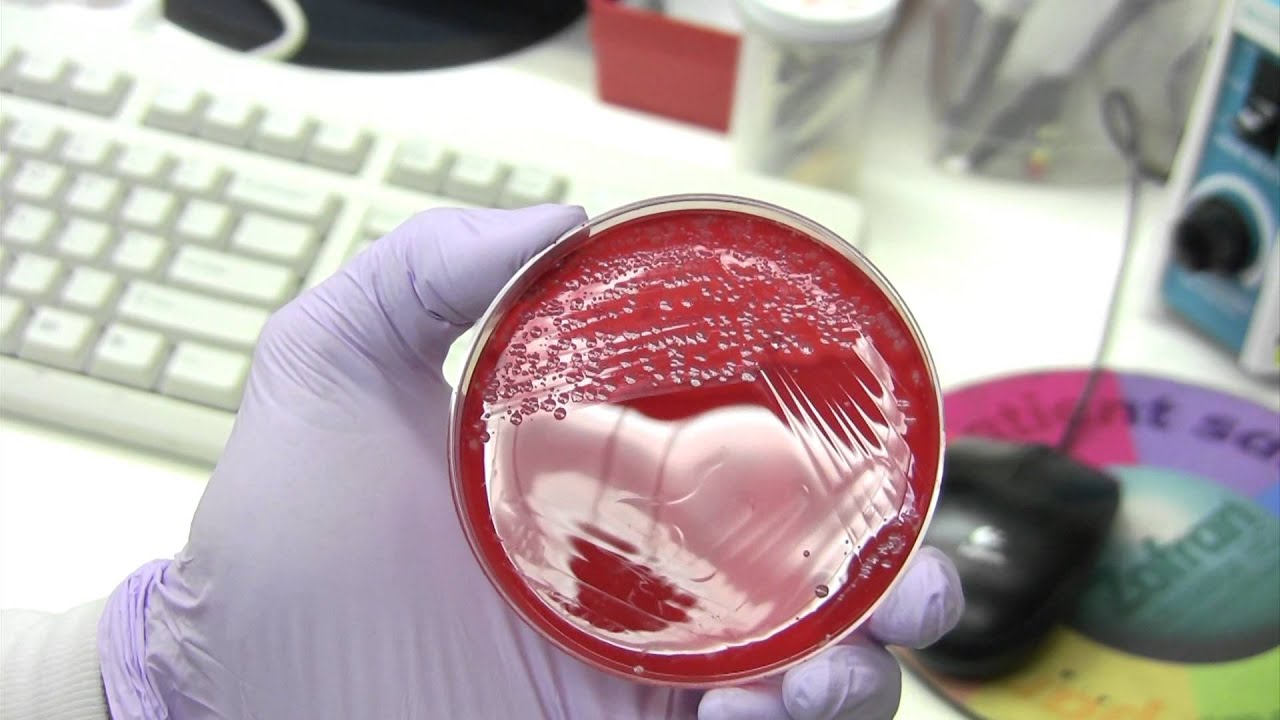
Esputo

Esputo
El esputo, conocido comúnmente también como flema, hace referencia a la mucosidad que se origina en los pulmones y que, en caso de infección o enfermedad en el aparato respiratorio, puede ser expulsado mediante la tos. Es importante tener en cuenta que el esputo no es sinónimo de saliva o escupitajo ya que forma parte del sistema inmunitario al protegernos de bacterias u otras sustancias nocivas que puedan atacar a los pulmones o vías respiratorias en caso de infección.
Así, gracias al espesor del esputo, las sustancias nocivas pueden ser atrapadas sin llegar a afectar a los pulmones o reduciendo la virulencia con la que lo hacen. Por ello, en caso de infección, suele ser expulsado a través de las vías respiratorias al toser. Además, el color del esputo puede proporcionar información sobre el tipo de infección o avance de la misma.

Por ello, un cultivo de esputo puede ser una forma sencilla de poder detectar y diagnosticar diferentes bacterias que pueden causar infección en pulmones o vías respiratorias. Del mismo modo, gracias al cultivo de esputo se puede obtener información detallada sobre el estado de la enfermedad pulmonar o el funcionamiento del tratamiento elegido para su cura. A través de una muestra de esputo obtenida de las vías respiratorias, los profesionales de la salud pueden realizar diferentes estudios de la infección pulmonar y de su evolución con el paso del tiempo.
